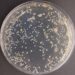

Kaune pradeda veikti specializuotas sveikatos centras, skirtas nutukimu, cukriniu diabetu ir kitomis susijusiomis lėtinėmis ligomis sergantiems pacientams.
Naujojo sveikatos centro veiklos principas – kitoks nei įprastai. Jame nevyks vienkartinių gydytojų specialistų konsultacijų, bet pacientams bus teikiamos ilgalaikės kompleksinės sveikatos priežiūros ir sveikatinimo paslaugos, atsižvelgiant į individualius jų poreikius.
Su pacientais centre dirbs visa specialistų komanda: suaugusiųjų ir vaikų gydytojai endokrinologai, kardiologai, oftalmologai, slaugytojos-diabetologės, medicinos psichologai, gyvensenos medicinos, fizinio aktyvumo specialistai, ergoterapeutai.
Diabetu ir kitomis susijusiomis ligomis sergantiems asmenims bus teikiamos individualios konsultacijos, mažose grupėse vyks kompleksinės sveikatinimo programos.
Naujasis sveikatos centras pavadintas Oskaro Minkovskio vardu, pagerbiant žymų daugiau nei prieš 100 metų Kaune gimusį gydytoją ir mokslininką, vieną iškiliausių to meto Vokietijos terapeutų, kuris pirmasis išsiaiškino pankreatinę cukrinio diabeto kilmę ir padėjo pamatus insulino atradimui bei šiuolaikinei diabetologijai.
Mirštamumas – vienas didžiausių Europos Sąjungoje
„Kalbant apie gyvensenos ligas, kaip nutukimas, 2 tipo cukrinis diabetas, svarbiausi sprendimai priimami ne gydytojo kabinete, o kiekvieną dieną paciento namuose. Ir būtent čia šiandienės medicinos rankos per trumpos“, – pastebi naujojo sveikatos centro vadovas, LSMU Medicinos fakulteto Endokrinologijos klinikos profesorius Jonas Čeponis.
Pasak profesoriaus, skiriant optimalų medikamentinį gydymą, šiuo metu ganėtinai gerai valdomas diabetu sergančių pacientų gliukozės kiekis kraujyje, todėl mažėja smulkiųjų kraujagyslių komplikacijų – diabetinės neuropatijos (nervų pažaida), retinopatijos (akių tinklainės pažaida) ir nefropatijos (inkstų pažaida) atvejų.
Tačiau stambiųjų kraujagyslių pažaidos, kuri prasideda gerokai iki diagnozuojant diabetą, atvejų skaičius – vis dar didžiulis ir sunkiai kontroliuojamas.
„Natūrali ligos eiga „nutukimas – atsparumas insulinui – 2 tipo cukrinis diabetas – aterosklerotinė širdies liga – mirtis”, deja, valdoma nepakankamai. Apskritai, sergamumas ir mirštamumas dėl širdies ir kraujagyslių ligų Lietuvoje – vienas didžiausių ES.
Tad svarbiausia priežastis, dėl kurios įsteigtas Oskaro Minkovskio sveikatos centras – kad būtų vieta, kurioje pacientas sau priimtinu tempu susipažintų su įrankiais valdyti ligą ir juos išmoktų taikyti savo gyvenime“, – pasakojo prof. J. Čeponis.
Įvairių sričių specialistai ir sisteminė pagalba
Kita aplinkybė, paskatinusi įsteigti specializuotą sveikatos centrą – suvokimas, kokių puikių ir patyrusių įvairių sričių specialistų turime šioms lėtinėms ligoms valdyti. Tačiau dabartinėje sveikatos sistemoje nėra sąlygų jiems visavertiškai bendradarbiauti, o ligoniams reikiamos paslaugos teikiamos fragmentiškai.
Tad naujasis sveikatos centras konsoliduos šios srities specialistų kompetencijas ir pacientams teiks tęstinę sisteminę pagalbą.
Oskaro Minkovskio sveikatos centras įsteigtas, bendradarbiaujant LSMU ir privačiam investuotojui. LSMU atstovai aktyviai dalyvauja valdant centrą. Puoselėjant universiteto misiją, centre išlaikomi sveikatos priežiūros veiklos, mokslinės ir akademinės veiklos vienovės pricipai. Numatoma, kad čia bus viena LSMU mokslinės veiklos ir mokymo bazių.
Naujoji įstaiga tobulins ir diegs naujas lėtinių ligų gydymo metodikas, ieškos naujų sprendimų įtraukiant ir įgalinant pacientus. Pasinaudojant naujomis technologijomis, pacientų nuotolinės stebėsenos galimybėmis, bus galima padėti vis didesniam pacientų ratui ir siekti didesnio paslaugų veiksmingumo.
„Tikimės, kad remiantis iš intervencinių programų gautais veiksmingumo įrodymais, mūsų paslaugos ateityje bus kompensuojamos iš valstybinės ligonių kasos ir bent dalis jų taps įprastinėmis visiems sergantiesiems šiomis ligomis“, – viltingai į ateitį žvelgė Oskaro Minkovskio sveikatos centro vadovas.
Pranešimą paskelbė: Rasa Masiokaitė, Lietuvos sveikatos mokslų universitetas